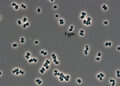
«Зомби-бактерия» из чистых комнат NASA могла пережить полёт к Марсу
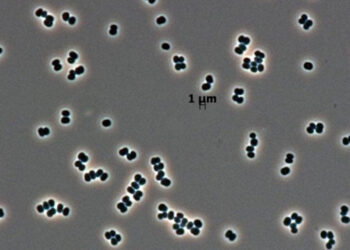
«Зомби-бактерия» из чистых комнат NASA могла пережить полёт к Марсу

Внедорожник BAIC BJ40, доступный на российском рынке с лета прошлого года, уже весной выйдет в России в версии с дизельным двигателем, о чем сообщила пресс-служба китайского бренда.
Компания BAIC также сообщила о запуске еще одной модели внедорожника – BJ60 – на российском рынке. Продажи начнутся этим летом.

Ожидается, что BAIC BJ40 получит турбированный бензиновый двигатель объемом 2,0 литра мощностью 163 лошадиные силы, он будет оснащен автоматической коробкой передач, а также полным приводом. В настоящее время модель предлагается в России с бензиновым двигателем объемом 2,0 литра и мощностью 225 л.с., восьмиступенчатой автоматической коробкой передач ZF и полным приводом.
Что касается модели BJ60, она была обновлена в ноябре 2023 года, получив новый дизайн передней части и гибридную систему на базе 1,5-литрового турбомотора. Новая версия BJ60 будет иметь двигатель объемом 2,0 литра и мощностью 266 лошадиных сил, а также восьмиступенчатую автоматическую коробку передач.
12 февраля 2024 в 16:48
Автор: Jin
| Источник: Российская газета